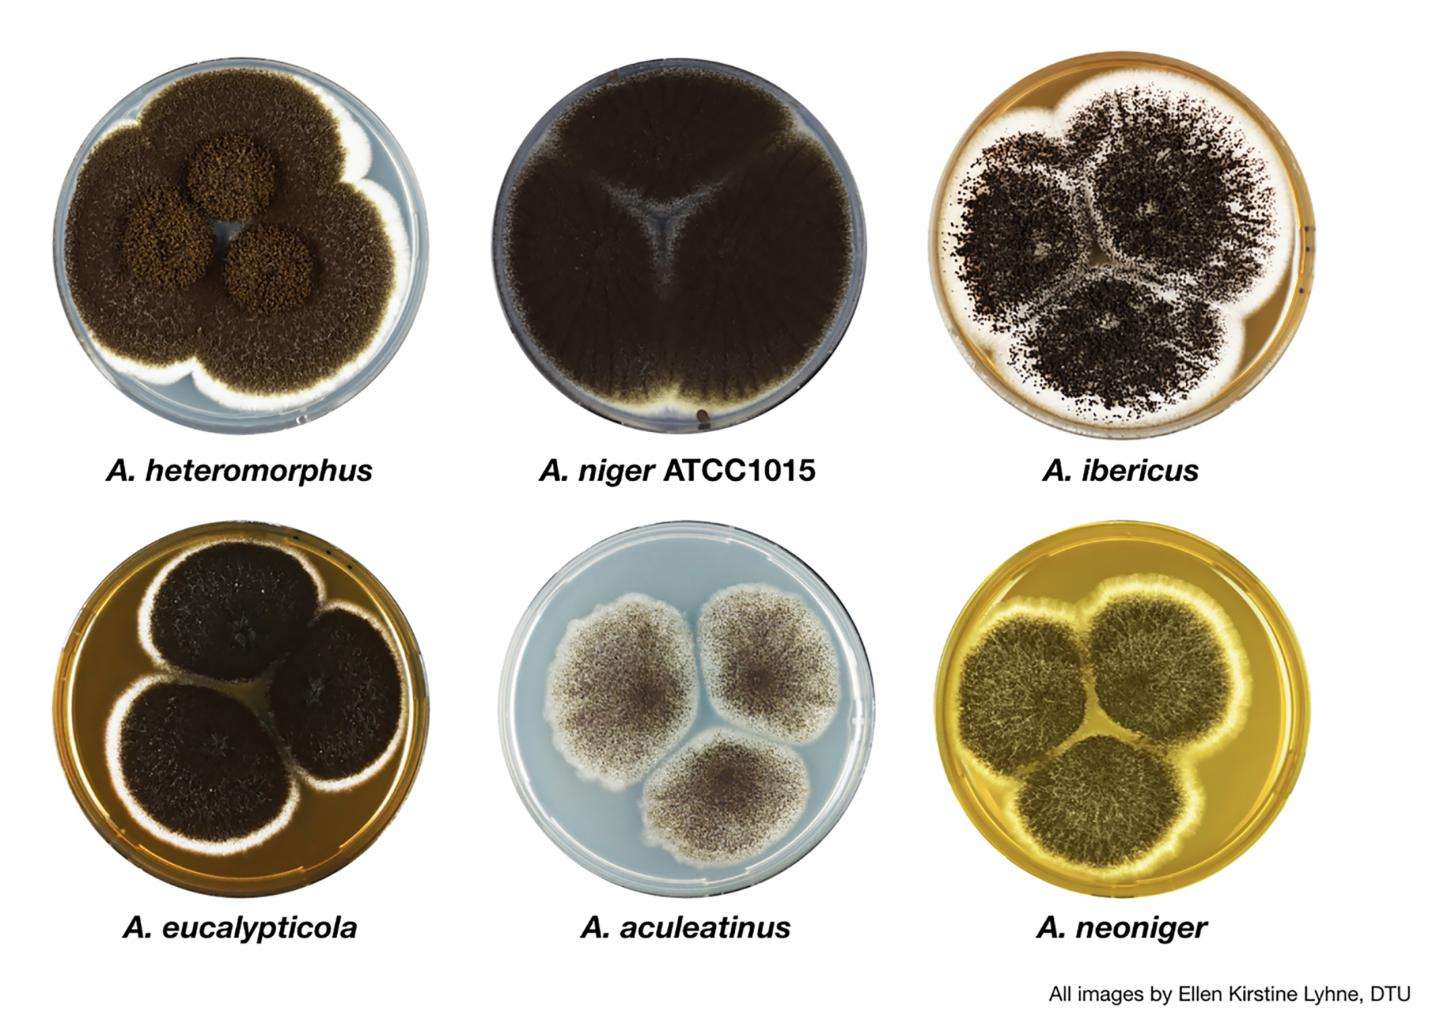
一克熟茶,普洱熟茶三年了能喝吗有毒吗

文/人间纪闻录
编辑/人间纪闻录

在普洱茶界,发烧友们经常会说:“普洱茶是所有爱茶人的最后一站”。他们把普洱茶奉为“琼浆玉液”,喝了普洱,其他茶便再难进口了。
可最近,视普洱茶如命的他们却犯了难。
“打假专业户”*舟子方**发表的一篇文章中,提出了一个观点:
“普洱茶细菌爆表,喝普洱茶等同于在喝脏水,更会致癌。”
由此,普洱茶被推上了风口浪尖,就连一天都少不了的人都在犹豫还要不要继续喝。
那么,普洱茶中是否真的含有致癌物?

普洱茶是发酵茶
市面上的普洱茶一般分为熟茶和生茶。
普洱生茶顾名思义就是生的,不需要经过人工“烹饪”,以自然的方式陈放而成。熟茶则是以云南大叶种晒青毛茶为原料,通过人工“发酵”,以特色的“渥堆发酵”形成。
因为这个步骤,熟茶更具有独特的陈香,也因为它让普洱茶备受争议。

“渥堆发酵”在原理上其实和家中平时腌酸菜一样,利用微生物的分解作用,使其拥有独特的味道。专家通过研究表示:
几乎所有发酵类的食物都具有“三菌发酵”的共性,也就是通过细菌、酵母菌和霉菌三种微生物共同的作用下完成发酵。
酵母菌就不用多说了,平时家里蒸馒头包子、面包甜点都会用到酵母发酵。
细菌好像天生被很多人误解,要知道细菌是微生物中的一个大类,益生菌、乳酸菌等。
而霉菌呢,大家本能的就会认为这东西恶心,食物腐烂发霉长出的绿毛,让人看了就会心里发怵。

霉菌种类众多,但在人们的认知里,好像任何东西只要跟霉菌沾边,那就是有毒的,而病菌中有一种叫黄曲霉的,更是一种致癌物质,毒性是*霜砒**的68倍。
但其实,并不是所有霉菌都含有毒性。就像生活中的酱油、醋、酒、酸奶等发酵食品,这些都要通过霉菌发酵,但从没听谁说过这其中含有致癌物。
那为何普洱茶会备受诟病呢?
普洱茶含有黄曲霉素吗?
在普洱茶的制作过程中,存放发酵是尤其重要的一步。
将青毛茶洒上水后用麻布覆盖,然后就会放在库房里进行存储发酵。而储存普洱茶的仓库有干湿两种,在正常情况下,因为温度和通风条件的差异,会使得干仓普洱发酵特别慢,面对市场大量的需求,这种方法并不可取。
因此,湿仓发酵普洱是最为常见的方法。
湿度一上来,发酵速度就会大大加快,因为大量的病菌开始产生并活动,那这种病菌是否是黄曲霉素呢?

在国内核心期刊《茶叶科学》上,有相关研究的科研工作者就发表过“普洱茶发酵过程中是否产生黄曲霉菌”为专题的科研论文。
实验是以2011年的青毛茶为对象,模拟茶叶发酵后,发现接种的黄曲霉菌可以在茶叶中生长和繁殖,并且在一开始,生长的速度惊人。但随着发酵的时间越来越长,黄曲霉素的生长和繁殖速度降低了,在发酵完成后,未在样品中检测出任何黄曲霉菌。
华南农业大学食品学院教授赵力超表示:
黄曲霉素最佳的生长温度在33℃-38℃之间,而渥堆发酵的温度一般在40℃-60℃,普洱加工的温度不适合黄曲霉生长,黑曲霉才是普洱发酵过程中的主角,占比高达80%,而黑曲霉大量生长的同时还会竞争性抑制黄曲霉的生长,降低黄曲霉的生物酶活性。
黑曲霉
伴随着黑曲霉产生的还有青霉、根曲霉。
黑曲霉在过程中将将宁转化为没食子酸,使得口感变得温和。将糖类转化为醇,再转化为酯类,散发出原本清新的茶香。不仅如此,黑霉素产生的有机酸、氨基酸还能让普洱更具鲜香的口感。
青霉可以降解茶中的纤维素,产生游离糖类,让茶水变得更加甘甜。
根曲霉则是分解果胶,软化茶叶,让茶味更加馥郁浓香。
这些霉菌不仅对身体没有坏处,反而有益。《本草纲目拾遗》中就有记载:普洱茶“苦涩、逐痰下气,刮肠通泄”。发酵后的普洱茶中含有大量的衍生物,能促进蛋白酶的分泌,有助于消化和预防便秘,消脂减糖。
别看黄曲霉和黑曲霉像是“同卵双生的双胞胎”,可它们却是天差地别。
随着普洱茶发酵的时间越来越长,水分越来越少,黑曲霉的数量就会随之降低,这时候,酵母菌就会替代黑曲霉,成为普洱茶后期发酵的主力军,控制茶堆中所有资源,继续抑制黄曲霉的生长。

酵母菌
也就是说,如果生产普洱茶的一切程序都正规,那么基本就不会产生黄曲霉素,更不存在致癌的可能。
那为什么,市面上仍检测出了含有黄曲霉素的普洱茶呢?
为什么市面上售卖的普洱茶中含有黄曲霉素?
2011年,7月,广州市疾控中心和中山大学公共卫生学院、南方医科大学等研究机构联合进行了一项关于普洱茶的调查研究。研究人员从广州的市场上,抽查了70个价格不等的格普洱茶的样品,平均价格在每斤15元左右,最低的每斤4元。
这其中有11%的样品中,黄曲霉素含量超出了国家标准。除了黄曲霉素外,还有伏马菌素、T2毒素以及呕吐毒素。
不仅如此,奥地利、德国等其他国家也对中国的209份普洱茶样品进行了检测,结果发现其中有23份检出了黄曲霉素,9份含量超标。

既然相关研究人员已经指出了普洱茶在发酵过程中基本上不会产生黄曲霉,那黄曲霉必定是来源于后期熟茶储存的环境、保存的条件和年份。
毕竟一样物品从厂家生产到消费者购买,其中各个环节都有可能产生其他状况。要知道,茶叶对存放是有要求的,不是说放在哪都行。
在这次的抽检中,研究人员就发现了在这70份普洱样品中,有一些是存放在“湿仓”当中,并与其他物品混合存放。
要知道,当温度在24℃至28℃之间,空气中的相对湿度达到80%时,黄曲霉素就会大量繁殖。也就表明,“湿仓”的环境很适合黄曲霉素的生长,再加上其他物品存放容易造成“交叉感染”,这样普洱茶上沾染黄曲霉素的风险就大大增加。
懂茶的人一般都会觉得普洱茶存放的时间越久,香味会越浓,价值也会越高。虽然这个观点没错,但要放在保存得当的前提下。如果保存不当,普洱茶会发霉,这样的茶叶不但没有价值,还会危害健康。

除了保存方式,保存时间也尤为关键。网上虽然一直流传着普洱茶越陈越香的说法,但这不代表它没有保质期。中国农业科学院茶叶研究所处长林智表示:
普洱茶最佳的保质期大概是10年,但若储存条件差,期限就会相应缩短。
再反观检测中,在广州市场上购买的普洱茶,大多都是肉眼可见的发霉变质,价格低廉,虽然这其中有黄曲霉素超标的,但是个例不代表普遍,如果一杆子打死了所有的普洱茶,那对普洱茶爱好者是不是不太公平呢?
而且,在检测中查出的黄曲霉素含量是每公斤8.52微克。这是什么概念?
一个人每天喝1000斤普洱茶,里面的黄曲霉素全部被人体吸收,再连续喝上3个月,这样才能达到一个60公斤成年人的致癌量。
更重要的一点是,黄曲霉素是难溶于水的,泡茶的时候基本不会进入茶汤,除非你嚼着茶叶吃下去,相信几乎很少人会有这个习惯吧。
其实不仅仅是普洱茶,任何食品保存不当或者制作原料劣质,都有可能导致霉变。所以,对于普洱茶致癌这种说法,大家大可不必相信,如果你喜欢,那就喝,但要是图便宜买些不合格或者霉变的产品,那就需要特别小心了。

如果爱茶,那就正确的买茶、喝茶、存茶
如何挑选普洱?
在市场或者超市挑选普洱茶时,作为消费者,唯一能评判好坏的就是外形。
普洱茶对于外行人来说有个致命的点,别的茶叶大多是清香,而普洱则是陈香,它的陈味与霉味道,在一定程度上极为相似,特别是在没有打开包装之前,光凭闻味道,是很容易将二者混淆的。
如果真有需求,可以让卖家提供已拆的成品再进行挑选。
一:看外形
正常条件保存下的普洱表面会有一层白霜,这一层薄薄的白色物质,大小均匀、不集块,不聚巢。
一旦霉变,就会在表面某一个部位产生霉斑,严重地长出白色绒毛或者绿色绒毛。

二:闻气味
普洱茶在用开水泡入后,叶片底部的味道最具代表性。茶叶的陈味是自然柔和的,就好似年代已久的木质家具散发出的深沉香气。
而霉味则是刺鼻的,就像南方梅雨季节时,一楼木质家具发霉后产生的潮味。
还有一点,品普洱茶,讲究的就是纯。有一些不良茶商会在发霉的普洱茶里加入菊花,用花香味掩盖霉味,如果大家在挑选的过程中遇到了这种情况,就一定要多加注意。
三:品茶汤
一杯茶好坏与否,第一口便能分晓。
陈化后的普洱茶入口柔,温和不刺激,茶香浓郁,不涩不苦,一口下去,喉咙都好像被净化了一般。
霉变后的茶味复杂刺激,难以下咽。

如何品尝普洱?
一:宜冲泡不宜煮
普洱属于发酵型的茶叶,相较于清茶而言,浓度会高一些。茶用水煮就会过浓, 而浓茶对肠胃刺激大,是不宜多喝的。熟茶一旦煮过后,一是闻不到香气,二则味道也不浓郁。
除此之外,在冲泡普洱时,建议将头道茶倒掉,清除茶叶上的灰尘后喝着会更安全。想要味道更醇正,建议多泡几次,一般在10-15道。
二:骨质疏松者不喝
普洱茶中除了含有营养物质之外,还有很多微量元素,其中就包括氟。长时间饮用普洱茶,氟元素与身体中的钙离子相结合,就会产生氟化钙,导致钙元素流失,骨质疏松的症状加重。
除了骨质疏松患者外,对骨密度下降的中老年人来说,普洱茶不建议多喝。

三:饭前饭后不宜大量饮用
饭前饭后喝太多普洱茶,会给肠胃造成负担,不但不利于消化吸收,还可能给其他器官带来损伤。如果实在想喝普洱茶,建议在饭前饭后半小时后。
如何存放普洱?
从前面我们可以得知,普洱茶中之所以含有黄曲霉,大多数原因都是因为储存方式有误,下来就告诉大家应该如何正确存放普洱茶。
一:注意防潮,适当通风
在南方很多地区,有着回南天、梅雨季节,当存茶的地方湿度达到75%以上时,黄曲霉素就会猛增。
因此紧闭门窗,防止湿气进入,借助风扇保持室内通风,让空气流动起来,保持村茶室里湿度相对稳定,带走多余的杂味。

二:密封保存
茶饼或者散茶一旦开封,“裸奔”的普洱或多或少都会吸收空气中的水分。如果长期存放,建议用瓦楞纸箱,纸箱的隔热效果较好,不用担心温度骤然变化,相对较厚的纸箱还有一定的吸水性,能保证内部茶叶不受潮。
不建议用紫砂壶存放茶叶,紫砂的材质时透气性较好的双重气孔结构,易让水汽渗入,茶叶受潮。
三:离地存放
存茶讲究离地存放,距离最好在10厘米以上,这样可以 有效的隔绝地面的湿气和潮气。有条件的,最好使用专门的货架。
除了地远离面之外,也要远离墙壁,阴雨天时,易湿难干的水泥中含有大量水汽,容易使得茶叶受潮。

结语:
近些年来,喜欢喝普洱茶的人越来越多,质疑声也越来越多,变成了所有茶中最具争议性的那一个。
其实普洱本性无毒,因为人们不正确的认知以及不良商家的恶意售卖。才使得它千疮百孔,遭人*制抵**。
如果你身边有爱喝普洱茶的人,请告诉他如何科学买茶、喝茶、存茶,切勿将谣言错误传递。